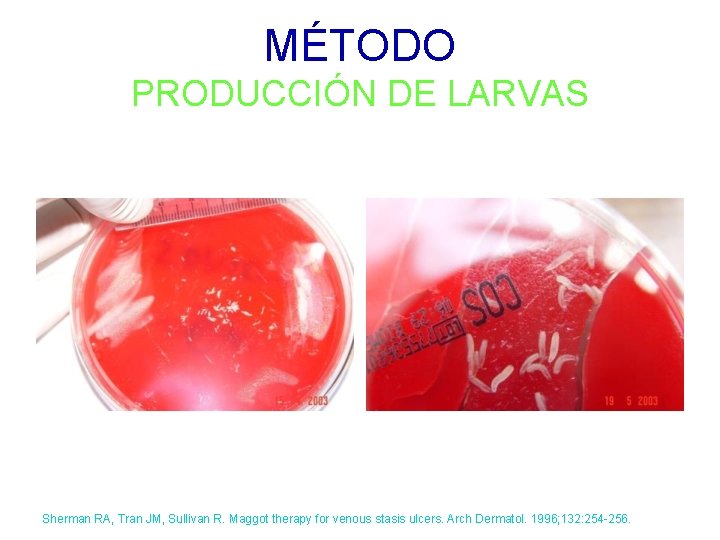
MÉTODO PRODUCCIÓN DE LARVAS Sherman RA, Tran JM, Sullivan R. Maggot therapy for venous

ESTUDIO COMPARATIVO DE LA EFICACIA DE LA LARVATERAPIA

- Slides: 41
ESTUDIO COMPARATIVO DE LA EFICACIA DE LA LARVATERAPIA PARA DESBRIDAR Y CONTROLAR LA CARGA BACTERIANA EN ÚLCERAS VENOSAS DR. JOSÉ CONTRERAS RUIZ dermayheridas@gmail. com CLÍNICA DE HERIDAS Y ESTOMAS DIVISIÓN DE DERMATOLOGÍA HOSPITAL GENERAL “DR. MANUEL GEA GONZÁLEZ”.
INTRODUCCIÓN LARVATERAPIA • LARVAS DE MOSCA (Lucilia sericata) • ESTERILIDAD (Desinfección) • DESBRIDAMIENTO • ANTIMICROBIANA Mumcuoglu KY. Maggot debridement therapy. Plast Reconstr Surg. 2007; 120: 1738 -9
INTRODUCCIÓN HISTORIA • NIKOLAI PIROGOV – (1810 -1881) – Guerra de Crimea – “Padre ruso de la LT” • WILIAM T BAER – – 1ª Guerra Mundial 1928 Johns Hopkins “Padre de la larvaterapia” Década 30 • Auge y desaparición Sokolov M, Kiyakovsky F. On typhus and fever in the former Southern Army in the end of 1855 and the beginning of 1856. St. Petersburg: 1857 Baer WS. The classic: The treatment of chronic osteomyelitis with the maggot (larva of the blow fly). 1931. Clin Orthop Relat Res. 2011; 469: 920 -944.
INTRODUCCIÓN HISTORIA • RONALD SHERMAN – 1985 Davydov L. Maggot therapy in wound management in modern era and a review of published literature. J Pharm Pract. 2011; 24: 89 -93.
INTRODUCCIÓN HISTORIA • RONALD SHERMAN – 1985 – Aprobación por Food and Drug Administration (2011) Davydov L. Maggot therapy in wound management in modern era and a review of published literature. J Pharm Pract. 2011; 24: 89 -93.
INTRODUCCIÓN MECANISMO DE ACCIÓN • DESBRIDAMIENTO MECÁNICO • DESTRUCCIÓN ENZIMÁTICA DEL TEJIDO NECRÓTICO – Colagenasas, lipasas, elastasas, entre otras • ACTIVACIÓN DEL SISTEMA INMUNOLÓGICO • REDUCCIÓN DE CARGA BACTERIANA
INTRODUCCIÓN MECANISMO DE ACCIÓN • REDUCCIÓN DE LA CARGA BACTERIANA – Competencia por el mismo sustrato – Antisépticos aislados • Ácido fenilacético y fenilacetaldehido • Especies reactivas de ammonio – Antibióticos (Defensinas) • Lucifensina 1, 2 • Otras defensinas – Destrucción de biopelículas • Polimicrobianas 3 • SARM 4 1) Andersen AS, et al. A novel approach to the antimicrobial activity of maggot debridement therapy. J Antimicrob Chemother 2010. 2) Cerovsky V, et al. Lucifensin, the long-sought antimicrobial factor of medicinal maggots of the blowfly Lucilia sericata. Cell Mol Life Sci. 2010; 67: 455 -466 3) Harris LG, et al. Disruption of Staphylococcus epidermidis biofilms by medicinal maggot Lucilia sericata excretions/secretions. Int J Artif Organs. 2009; 32: 555 -564 4) Bowling FL, Salgami EV, Boulton AJ. Larval therapy: a novel treatment in eliminating methicillin-resistant Staphylococcus aureus from diabetic foot ulcers. Diabetes Care. 2007; 30: 370 -371.
INTRODUCCIÓN EFICACIA CLÍNICA • LARVATERAPIA – Pie diabético • Mas rápida y más efectiva que los hidrogeles (no el mas utilizado) • Mas efectiva que el “cuidado estándar” – Úlcera venosa • Estudios abiertos • Ninguno – Cirugía (Legrado) vs. Larvaterapia – Antimicrobianos (SDP) vs. Secreciones de las larvas 1) Sherman RA. Wound Repair Regeneration 2000; 8: 327 2) Wayman J. J Tissue Viability 2000; 10: 91 -4.
INTRODUCCIÓN ÙLCERA VENOSA • Causa mas frecuente de consulta en CDHE – Prevalencia 3% población adulta – Tiempo de evolución prolongado – Afección a la calidad de vida – Manejo • Compresión • Adecuado desbridamiento • Terapia avanzada de la herida Contreras-Ruiz J, Escotto-Sanchez I, Cobo-Morales JF. Úlceras venosas. In: Contreras-Ruiz J, editor. Abordaje y Manejo de las Heridas. Mexico: Intersistemas Editores; 2013. p. 271 -295. Engelhardt M, Spech E, Diener H, Faller H, Augustin M, Debus ES. Validation of the disease-specific quality of life Wuerzburg Wound Score in patients with chronic leg ulcer. Vasa. 2014; 43: 372 -379.
OBJETIVO • Ensayo clínico controlado con evaluador ciego • Eficacia de la larvaterapia comparada con legrado y aplicación de sulfadiazina de plata (SDP) para desbridar y controlar la carga bacteriana en úlceras venosas
MÉTODO DISEÑO • • Clínico Experimental Prospectivo Comparativo Aleatorizado Controlado Evaluador ciego
MÉTODO CRITERIOS • Úlceras venosas • >6 sem evol • Reclutamiento: 1 año • Excluimos – Uso de antibióticos tópicos 1 sem antes – Diabetes – Inmunosupresión
MÉTODO PRODUCCIÓN DE LARVAS Sherman RA, Tran JM, Sullivan R. Maggot therapy for venous stasis ulcers. Arch Dermatol. 1996; 132: 254 -256.
MÉTODO PRODUCCIÓN DE LARVAS Sherman RA, Tran JM, Sullivan R. Maggot therapy for venous stasis ulcers. Arch Dermatol. 1996; 132: 254 -256.
MÉTODO SELECCIÓN DE TRATAMIENTO CONVENCIONAL LARVATERAPIA (10 Pacientes) ANESTÉSICO + DESBRIDAMIENTO (Legrado) + SDP TÓPICA + APÓSITO ADECUADO (DE ACUERDO AL EXUDADO) + COMPRESIÓN CONTINUA LARVATERAPIA + APÓSITO ADECUADO (DE ACUERDO AL EXUDADO) + POSTERIOR COMPRESIÓN VS.
MÉTODO PARÁMETROS • Evaluaciones: Basal y 4 semanas de seguimiento • Evaluador ciego • Tamaño de la herida (largo x ancho) • % necrosis, fibrina, granulación e islas de epitelio • Cantidad de exudado – Tanto por el paciente como el investigador – Paciente • Dolor, olor y ansiedad – Escala visual • Carga bacteriana (biopsias cuantitativas) 1) Sherman RA. Wound Rep Reg 2002; 10: 208 -14
MÉTODO APLICACIÓN DE LA LARVATERAPIA
MÉTODO APLICACIÓN DE LA LARVATERAPIA
MÉTODO APLICACIÓN DE LA LARVATERAPIA
MÉTODO APLICACIÓN DE LA LARVATERAPIA
MÉTODO APLICACIÓN DE LA LARVATERAPIA
MÉTODO MICROBIOLOGÍA • • Sacabocados 4 mm lecho de la herida Biopsia cuantitativa UFC/g tejido Aerobios & Anaerobios
MÉTODO ANÁLISIS • • BMDP-7 Variable explicativa – Grupo I o II Estadística descriptiva Estadística inferencial – Diversas técnicas estadísticas • Fisher, Kruskal-Wallis, Wilcoxon – Dos colas (alfa=0. 05) • Valoración intragrupal e intergrupal
RESULTADOS POBLACIÓN Evaluados 52 Seleccionados 19 10 H: 9 M Eliminados 2 - Pèrdida al seguimiento - Dislalia Larvaterapia 10 Control 9 Larvaterapia 8 Control 9 Eliminados 0
RESULTADOS VALORES INICIALES Grupo LT Grupo Control Mediana Mínimo Máximo Mann-Whitney ‡ p= Edad (años) 77. 5 53 93 56 42 79 74. 5 0. 01* Meses de evolución 18. 5 4 408 84 3 180 31 0. 25 Largo (cm) 8. 89 4 11. 69 7. 3 1. 8 12. 3 49 0. 45 Ancho (cm) 3. 09 2. 09 10. 39 3. 5 0. 9 7. 9 42 0. 89 Área (cm 2) 23. 13 9. 23 105. 04 28 2. 16 97. 17 49 0. 45 Granulación (%) 25 5 95 30 10 90 35. 5 0. 65 Fibrina (%) 70 5 93 55 10 85 46. 5 0. 59 Necrosis (%) 0 0 20 5 0 15 27 0. 17 Exudado 6 3 9 6 3 10 39. 5 0. 92 Olor 2 0 9 2 0 6 49 0. 43 Dolor 8 0 10 5 0 10 46 0. 61 Ansiedad 5 0 10 5 0 8 42 0. 89
RESULTADOS INTRAGRUPAL • AMBOS GRUPOS – Reducción significativa de dimensiones, mejora del lecho de la herida, disminución de exudado y de dolor • LARVATERAPIA – Aumento en la percepción de olor – Aumentó la ansiedad (no significativo)
RESULTADOS COMPARACIÓN INTERGRUPAL Grupo LT Grupo Control Mediana Mínimo Máximo Mann-Whitney ‡ p= Largo (cm) 6. 65 4. 50 13. 19 5. 3 0 11. 8 37. 5 0. 09 Ancho (cm) 2. 84 1. 70 11. 50 3. 3 0 8. 5 34. 5 0. 20 Area (cm 2) 14. 82 7. 07 96. 41 19. 18 0 78. 77 36 0. 14 Granulación (%) 90 40 100 60 0 90 36. 5 0. 12 Fibrina (%) 10 0 60 20 0 100 17. 5 0. 35 Necrosis (%) 0 0 10 0 28 0. 31 Exudado 2 2 3 3 0 6 40 0. 04* Olor 7 0 10 3 0 6 41. 5 0. 02* Dolor 6 0 10 2. 14 0 5 38. 5 0. 07 Ansiedad 7 0 9 0 0 5 41. 5 0. 02* Carga bacteriana
RESULTADOS LT vs. Control Semana 4 Características de la herida • Tamaño, Vel. cicatrización, % disminución en áreas, necrosis y granulación fueron comparables en ambos grupos • El exudado se redujo con LT
RESULTADOS CLÍNICOS - LECHO BASAL SEMANA 4
0 2 4
RESULTADOS LT vs. Control Semana 4 Síntomas & Efectos Colaterales • El dolor fue comparable en ambos grupos – Moderado (nunca mayor a 6) • El olor y la ansiedad del paciente fueron mayores con LT • Ningún efecto colateral severo • 8 eventos de fuga (ningún paciente mas de 1)
RESULTADOS MICROBIOLOGIA • 41 organismos diferentes aislados – Grampositivos, gramnegativos y anaerobios • Reducción global muy significativa de carga bacteriana en grupo de LT • Mayor significancia en subgrupo de grampositivas
RESULTADOS LT vs Control Semana 4 • MICROBIOLOGÍA
DISCUSIÓN • REINTRODUCIDA A LAT-AM 2001 – CDHE. Dermatología. HGDMGG. • Hay pocos estudios comparativos controlados – Principalmente series de casos – En pie diabético vs hidrogel • No todos los pacientes pueden recibir Qx – Contraindicación – Costo – Logística
DISCUSIÓN • LT vs. SDP + CURETAJE: – El uso de LT fue tan eficaz como el manejo quirúrgico + antimicrobiano • Reducción en el tamaño • Mejora del lecho de la herida – Aumento de granulacion y reduccion de necrosis y “fibrina” – EXUDADO SE REDUJO CON LT • ¿Efecto indirecto? – Menor necrosis – Menor carga bacteriana
DISCUSIÓN • LT vs. SDP + CURETAJE: – SINTOMATOLOGÍA Y TOLERABILIDAD • MISMA CALIFICACIÓN DE DOLOR • OLOR Y ANSIEDAD MAS COMUNES CON LT – CARGA BACTERIANA • Mucho mas eficaz la LT que 2 métodos conocidos de reducción de C. B. • Previamente descrito su papel sobre biopelículas • Presencia de péptidos antimicrobianos • Especialmente grampositivos (incluye SARM)
DISCUSIÓN • TAMAÑO DE LOS GRUPOS PEQUEÑO • USO DE ESTÁNDAR DE ORO – ¿Menos evidente la diferencia?
CONCLUSIÓN • LT es superior en el control de la carga bacteriana • LT es tan útil para desbridar y favorecer la cicatrización de la herida como el desbridamiento quirúrgico con legra en úlceras venosas
AGRADECIMIENTOS • • • Dr. Luciano Domínguez-Soto Dra. Maria Teresa Hojyo-Tomoka Dra. Judith Guadalupe Domínguez-Cherit Dr. Adán Fuentes-Suárez Biol. Sara Arroyo-Escalante Quim. David Moncada-Barron Dra. María Cristina Sosa-de-Martínez Dr. Ernesto Maravilla-Franco Ronald Sherman, MD
MUCHAS GRACIAS DEPARTAMENTO DE DERMATOLOGÍA